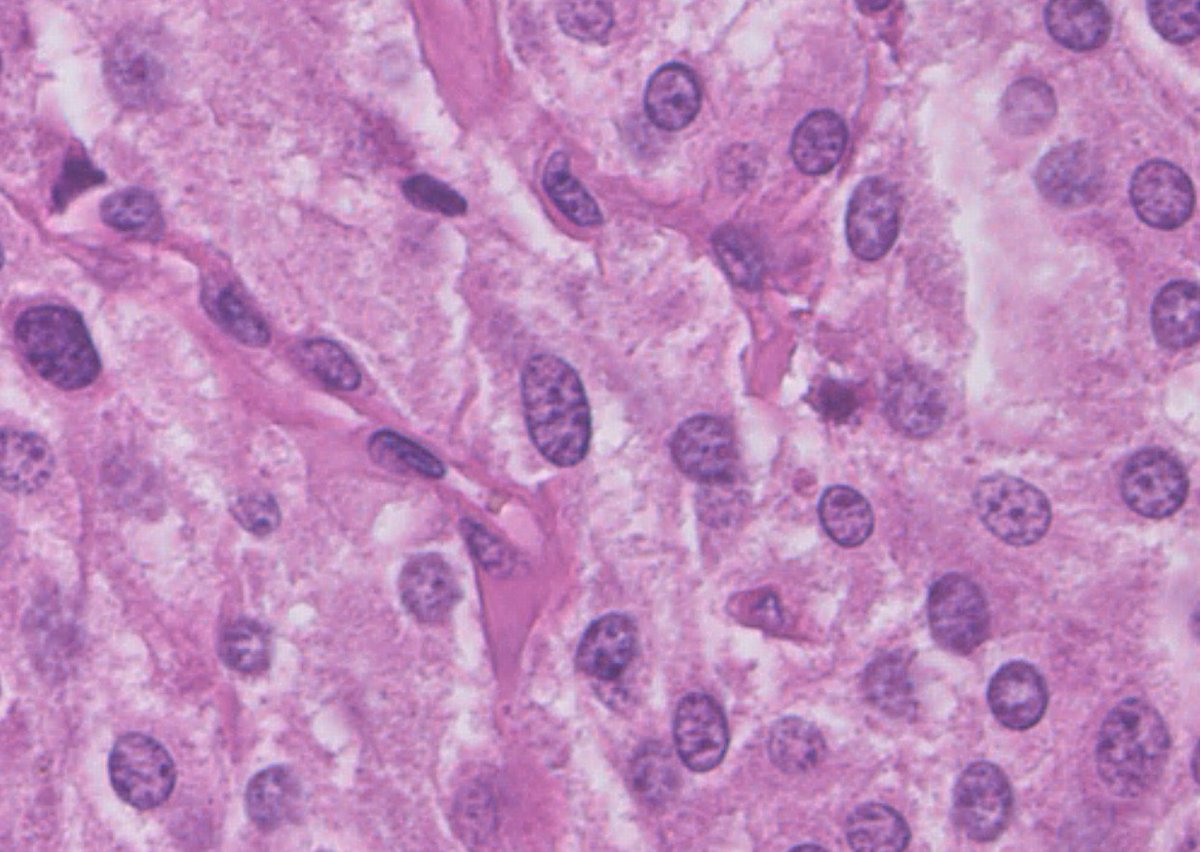
Woman, 28 yo. Vaginal nodule.
What do you think?

#pathology #PathTwitter

王成 Cheng Wang
@cwang668
DCP diagnostician
ID: 2347411797
16-02-2014 19:51:02
323 Tweet
69 Takipçi
1,1K Takip Edilen



"Two-in-one": lung AC in a pleural effusion: the same cells stained with papanicolaou and then with TTF1. "Cytopathology, doing more with less...."🔬✌️🎯💯🔝 Sociedad Española de Citología SEAP-IAP Cytopathology.org International Academy Cytology




1/4 Dedicated to the memory of Dr Ondrej Hes x.com/GU_Path_Societ… Adult, medullary based kidney tumour - large discohesive polygonal, rhabdoid cells - multinucleated cells - cytoplasmic vacuoles #PathTwitter #PathResidents #Pathology #GUPath Ahmad Dhia GU Pathology Society (GUPS)




Avraham Z. Cooper, MD 🩺 Cannon ball app in lung via hematogenous spread Choriocarcinoma..raised hcg levels Other signs- • hyperthyroidism( as alpha subuit of hcg~ TSH,Lh,fsh) •Gynecomastia D/D: CRASH C- CHORIOCARCINOMA R- RCC A- ADRENAL S- SYNOVIAL SARCOMA H- his- prostate Her- endometrial


NR4A3 immunocytochemistry can be used directly on FNAC conventional smears & liquid-based cytology to reliably distinguish acinic cell carcinoma from its mimickers. This may be useful in cases where a cell block preparation is unavailable or inadequate. acsjournals.onlinelibrary.wiley.com/doi/full/10.10…